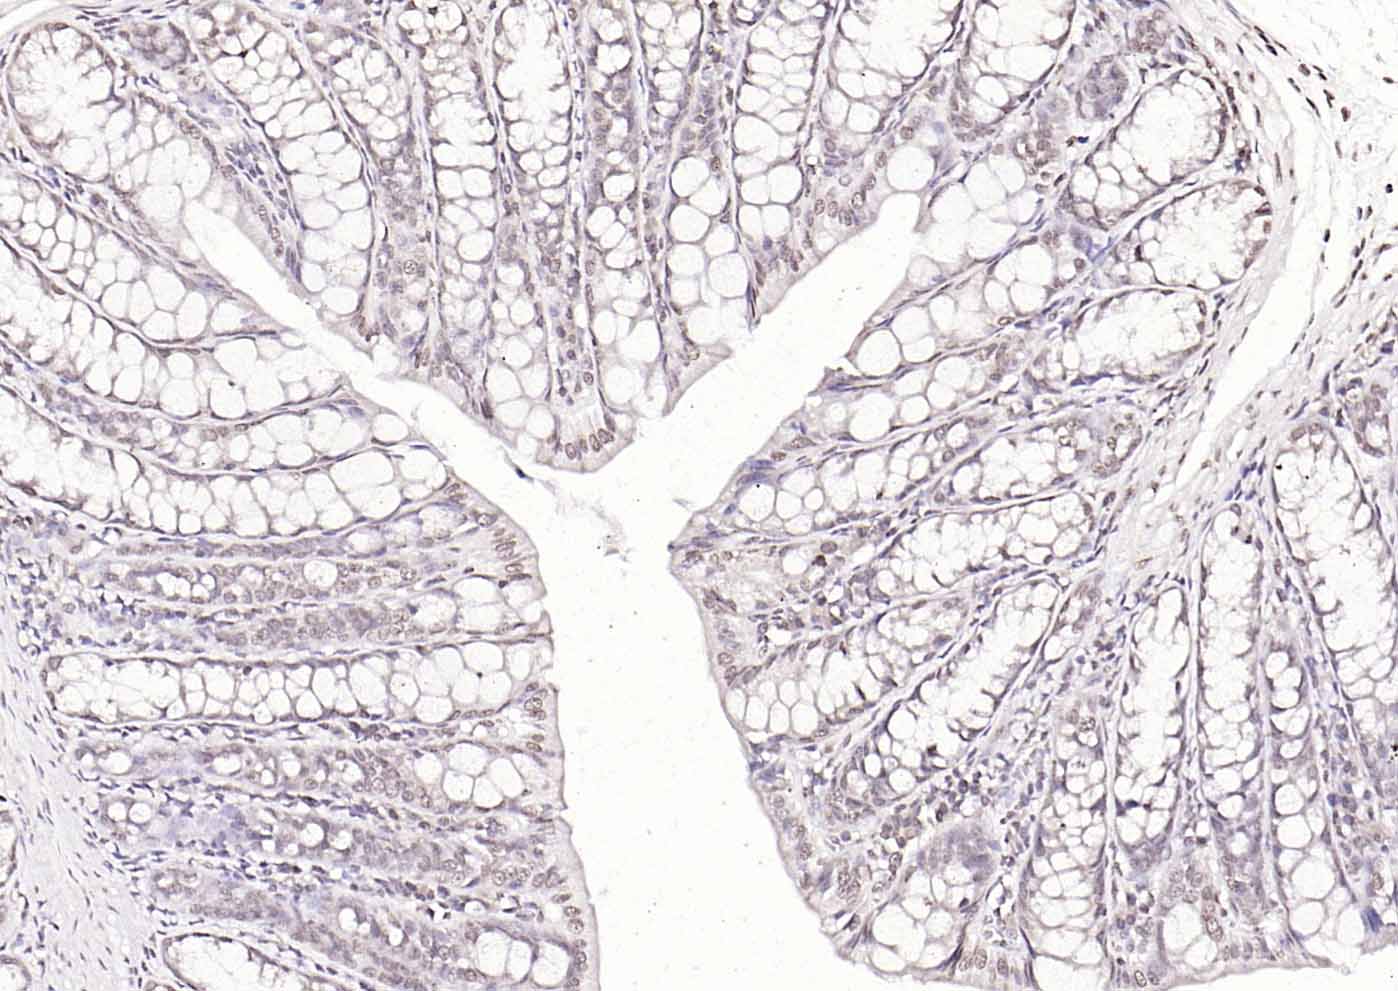
产品细节图片9

相关产品推荐更多 >

MAK3/C14orf35 Rabbit pAb, HRP conjugated(bs-18638R-HRP)-100ul
¥2980
LPPR2 Rabbit pAb(bs-18352R)-50ul/100ul/200ul
¥1180
Neuroglycan C Rabbit pAb(bs-11323R)-50ul/100ul/200ul
¥1180
Caspase-1 p20 Rabbit pAb, PerCP-Cy5.5 conjugated(bs-10442R-PerCP-Cy5.5)-100ul
¥2980
KCNQ2 Rabbit pAb, PE-Cy5 conjugated(bs-11728R-PE-Cy5)-100ul
¥2980
万千商家帮你免费找货
0 人在求购买到急需产品
- 详细信息
- 文献和实验
- 技术资料
- 应用范围:
产品信息以Bioss网站为准
- 规格:
50ul/100ul/200ul
| 规格: | 50ul | 产品价格: | ¥1180.0 |
|---|---|---|---|
| 规格: | 100ul | 产品价格: | ¥1980.0 |
| 规格: | 200ul | 产品价格: | ¥2800.0 |
| 产品编号 | bs-16783R |
| 英文名称 | KLF12 Rabbit pAb |
| 中文名称 | 锌指转录抑制因子KLF12抗体 |
| 英文别名 | 2700063E05Rik; AI225908; AI315654; AP-2 repressor; AP-2rep; AP-2rep transcription factor; AP2REP; B130052C06Rik; D530033K05Rik; HSPC122; KLF12; KLF12 zinc finger transcriptional repressor; KLF12_HUMAN; Krueppel like factor 12; Krueppel-like factor 12; OTTHUMP00000018503; Transcriptional repressor AP 2rep; Transcriptional repressor AP-2rep. |
| 产品应用 | WB=1:500-2000, IHC-P=1:100-500, IHC-F=1:100-500, IF=1:100-500 Not yet tested in other applications. |
| 交叉反应 | Human, Mouse, Rat (Chicken, Dog, Horse, Rabbit, Sheep) |
| 抗体来源 | Rabbit |
| 免疫原 | KLH conjugated synthetic peptide derived from human KLF12 |
| 亚型 | IgG |
| 性状 | Liquid |
| 纯化方法 | affinity purified by Protein A |
| 克隆类型 | Polyclonal |
| 理论分子量 | 44 kDa |
| 浓度 | 1mg/ml |
| 储存液 | 0.01M TBS (pH7.4) with 1% BSA, 0.02% Proclin300 and 50% Glycerol. |
| 研究领域 | Epigenetics and Nuclear Signaling > Transcription > Other factors Epigenetics and Nuclear Signaling > Transcription > Transcription Factors |
| 亚细胞定位 | Nucleus. |
| 相似性 | Belongs to the Sp1 C2H2-type zinc-finger protein family. Contains 3 C2H2-type zinc fingers. |
| 功能 | Confers strong transcriptional repression to the AP-2-alpha gene. Binds to a regulatory element (A32) in the AP-2-alpha gene promoter. |
| 保存条件 | Shipped at 4℃. Store at -20℃ for one year. Avoid repeated freeze/thaw cycles. |
| 注意事项 | This product as supplied is intended for research use only, not for use in human, therapeutic or diagnostic applications. |
| 背景资料 | Activator protein-2 alpha (AP-2 alpha) is a developmentally-regulated transcription factor and important regulator of gene expression during vertebrate development and carcinogenesis. The protein encoded by this gene is a member of the Kruppel-like zinc finger protein family and can repress expression of the AP-2 alpha gene by binding to a specific site in the AP-2 alpha gene promoter. Repression by the encoded protein requires binding with a corepressor, CtBP1. Two transcript variants encoding different isoforms have been found for this gene. [provided by RefSeq, Jul 2008] |
| 应用 | 推荐稀释比例 |
| {WB} | {1:500-2000} |
| {IHC-P} | {1:100-500} |
| {IHC-F} | {1:100-500} |
| {IF} | {1:100-500} |


Lane 1: Human HepG2 cell lysates
Lane 2: Human 293T cell lysates
Lane 3: Human Jurkat cell lysates
Lane 4: Human Raji cell lysates
Primary: Anti-KLF12 (bs-16783R) at 1/1000 dilution
Secondary: IRDye800CW Goat Anti-Rabbit IgG at 1/20000 dilution
Predicted band size: 44 kDa
Observed band size: 65 kDa

风险提示:丁香通仅作为第三方平台,为商家信息发布提供平台空间。用户咨询产品时请注意保护个人信息及财产安全,合理判断,谨慎选购商品,商家和用户对交易行为负责。对于医疗器械类产品,请先查证核实企业经营资质和医疗器械产品注册证情况。
 文献和实验
文献和实验[IF={{ 2.754 }}] {Wu, Guoxian. et al. Circ-RNF111 aggravates the malignancy of gastric cancer through miR-876-3p-dependent regulation of KLF12. World J Surg Oncol. 2021 Dec;19(1):1-12} {WB,IHC} {Human}
[IF={{ 2.626 }}] {Zhao, Gang. et al. LINC02381, a sponge of miR-21, weakens osteogenic differentiation of hUC-MSCs through KLF12-mediated Wnt4 transcriptional repression. 2021 Nov 15} {WB} {Mouse,Human}
[IF={{ 11.1 }}] {Fanxiang Meng. et al. Tumor necrosis factor–like cytokine 1A plays a role in inflammatory bowel disease pathogenesis. P NATL ACAD SCI USA. 2023 Aug;120(34):e2120771120} {IF} {Mouse}
= NAL), appears to form upon oxidative cyclization of the nonfluorescent 2:1 lysine-HNE Michael adduct-Schiff base cross-link (Scheme 1). Polyclonal antibody (PAb) to the NAL-HNE fluorophore was raised in rabbit and found to be highly specific
GE Healthcare Benzamidine Sepharose™ 6B is p-aminobenzamidine covalently attached to Sepharose 6B by the epoxy coupling method. p-Aminobenzamidine (PAB), is a synthetic inhibitor of trypsin-like serine protease. Trypsin and trypsin
Nucleic Acid Programmable Protein Arrays: Versatile Tools for Array‐Based Functional Protein Studies
.g., Sigma) 50 mg/ml bis‐sulfosuccinimdylsuberate (BS3 ;Pierce, cat. no. PI 21580) in dimethylsulfoxide (DMSO) 5 mg/ml
 技术资料
技术资料暂无技术资料 索取技术资料






